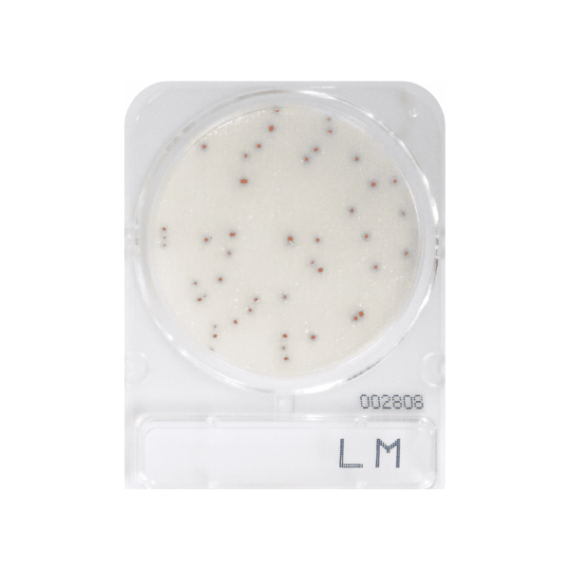
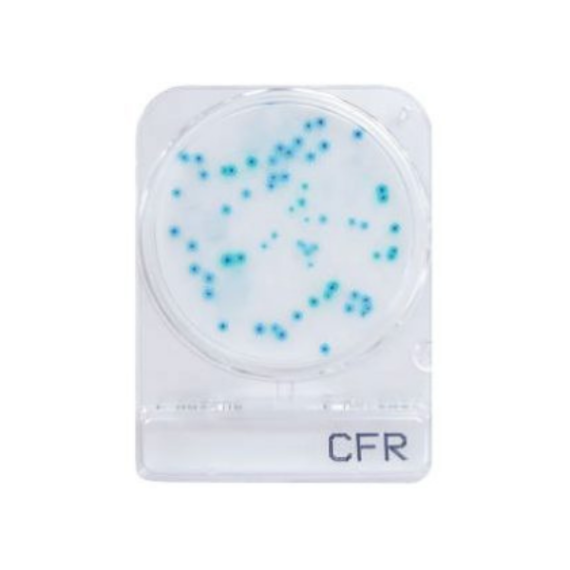

- ANASAYFA
- KURUMSAL
- HAKKIMIZDA
- EĞİTİM ve DANIŞMANLIK
- HABERLER
- Corona Hijyen Ölçümü
- Corona Dezenfeksiyon
- Corona Dezenfeksiyon Ölçümü
- Dezenfektan Kontrol Cihazı
- Bakteri Ölçüm Cihazı
- Virüs Ölçüm Cihazı
- Hijyen Kontrol Cihazı
- ATP Hijyen Monitörü
- Virüs ve Bakteri Kontrolü
- Hazır Besiyeri
- ATP Ölçüm Cihazı
- ADP Ölçüm Cihazı
- AMP Ölçüm Cihazı
- Hastaneler İçin Virüs Ölçüm Cihazı
- Hastaneler İçin Bakteri Ölçüm Cihazı
- Tıbbi Cihazlar Virüs Ölçümü
- Tıbbi Cihazlar Bakteri Ölçümü
- TEMSİLCİLİKLER
- ÜRÜNLER
- VİDEOLAR
- BLOG
- İLETİŞİM